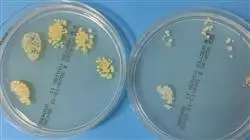
##IMAGE##

Университетская квалификация
Крупнейшая в мире школа питания”
Презентация
Благодаря данному Курсу профессиональной подготовки вы создадите более полные и комплексные планы питания, которые способствуют здоровому поддержанию кожи”

Связь между дерматологическими заболеваниями и микробиотой кожи была широко изучена в последние годы. В действительности, было показано, что дисбаланс в количестве и типе микроорганизмов, обитающих в этом органе, может привести к разнообразным проблемам со здоровьем, ухудшая качество жизни пациента.
Например, различные исследования показали, что уменьшение числа стафилококков и увеличение количества грибов рода Malassezia являются факторами риска возникновения экземы. Кроме того, было доказано, что сокращение популяции полезных бактерий, таких как лактобациллы, связано с повышенным риском развития псориаза.
Поскольку воздействие через питание является одним из наиболее эффективных решений, данный Курс профессиональной подготовки обеспечит диетологам высокую подготовку для совершенствования их планов питания, углубляясь в функционирование микробиоты кожи. Таким образом, в рамках программы студенты познакомятся со структурой кожи и ее микробным составом, различая роды, виды и штаммы микробиоты в целом. Также они проанализируют различные компоненты иммунной системы и органы, участвующие в ее иммунитете.
Этот полный курс можно пройти дома или где угодно благодаря удобствам, предоставляемым TECH. Вам понадобится только интернет-соединение для доступа к Виртуальному кампусу, через который вы получите доступ к обширной цифровой библиотеке ресурсов с последними знаниями по теме.
Положите конец наиболее распространенным сегодня дерматологическим заболеваниям с помощью диетологического вмешательства"
Данный Курс профессиональной подготовки в области микробиоты кожи содержит самую полную и современную научную программу на рынке. Основными особенностями обучения являются:
- Разбор практических кейсов, представленных экспертами в области микробиоты кожи
- Наглядное, схематичное и исключительно практическое содержание курса предоставляет научную и практическую информацию по тем дисциплинам, которые необходимы для осуществления профессиональной деятельности
- Практические упражнения для самооценки, контроля и улучшения успеваемости
- Особое внимание уделяется инновационным методологиям
- Теоретические занятия, вопросы эксперту, дискуссионные форумы по спорным темам и самостоятельная работа
- Учебные материалы курса доступны с любого стационарного или мобильного устройства с выходом в интернет
Получите самые современные знания в этой области, проанализировав структуру кожи и ее микробный состав, чтобы усовершенствовать свои стратегии питания"
В преподавательский состав программы входят профессионалы отрасли, которые привносят в обучение свой профессиональный опыт, а также признанные специалисты из ведущих сообществ и престижных университетов.
Мультимедийное содержание программы, разработанное с использованием новейших образовательных технологий, позволит специалисту проходить обучение с учетом контекста и ситуации, т.е. в симулированной среде, обеспечивающей иммерсивный учебный процесс, запрограммированный на обучение в реальных ситуациях.
Структура этой программы основана на проблемно-ориентированном обучении, с помощью которого специалист должен попытаться решить различные ситуации из профессиональной практики, возникающие в течение учебного курса. В этом специалисту поможет инновационная интерактивная видеосистема, созданная признанными экспертами.
Отвечайте требованиям пациентов к высокому уровню подготовки в области микробиоты и станьте востребованным современным диетологом"

Изучите факторы риска развития наиболее распространенных дерматологических заболеваний, чтобы предотвратить их с помощью питания"
Учебный план
Микрофлора кожи является одним из основных элементов микробиоты человека, поэтому она заслуживает самого передового и актуального учебного материала. Поэтому студенты углубятся в изучение физиологии кожи и кожной иммунной системы, анализируя возникновение дисбактериоза и заболеваний, которые он вызывает. Кроме того, программа предложит им глобальную перспективу микробиоты остальных частей организма, чтобы развить целостные знания и выделиться в этой области с большим профессиональным потенциалом.

Учебный план, с которым вы изучите физиологию кожи, углубляясь в эпидермис, дерму и гиподерму”
Модуль 1. Микробиота кожи
1.1. Физиология кожи
1.1.1. Структура кожи: Эпидермис, дерма и гиподерма
1.1.2. Функции кожи
1.1.3. Микробный состав кожи
1.2. Факторы, регулирующие тип бактериальной флоры на коже
1.2.1. Потовые железы, сальные железы, десквамация
1.2.2. Факторы, изменяющие экологию кожи и ее микробиоту
1.3. Кожная иммунная система. Эпидермис — важный элемент нашей защиты
1.3.1. Эпидермис — важный элемент нашей защиты
1.3.2. Элементы кожной иммунной системы: Цитокины, кератиноциты, дендритные клетки, лимфоциты, антимикробные пептиды
1.3.3. Влияние микробиоты кожи на иммунную систему кожи. Staphylococcus epidermidis, Staphylococcus aureus
1.4. Изменение нормальной кожной микробиоты (дисбиоз) и нарушение барьерной функции
1.4.1. Изменение барьерной функции
1.5. Запущенные кожные патологии
1.5.1. Псориаз (Streptococcus pyogenes)
1.5.2. Акне vulgaris
1.5.3. Атопический дерматит
1.5.4. Розацеа
1.6. Влияние использования пробиотиков в профилактике и лечении различных кожных заболеваний
1.7. Текущие направления исследований
Модуль 2. Микробиота. Микробиом. Метагеномика
2.1. Определение и взаимосвязь между ними
2.2. Состав микробиоты: роды, виды и штаммы
2.2.1. Группы микроорганизмов, которые взаимодействуют с человеком: Бактерии, грибки, вирусы и простейшие
2.2.2. Ключевые понятия: Симбиоз, комменсализм, мутуализм, паразитизм
2.2.3. Микробиота коренного населения
2.3. Различные микробиоты человека. Общая информация о его эубиозе и дисбиозе
2.3.1. Микробиота желудочно-кишечного тракта
2.3.2. Микробиота полости рта
2.3.3. Микробиота кожи
2.3.4. Микробиота респираторного аппарата
2.3.5. Микробиота мочевыводящих путей
2.3.6. Микробиота половых путей
2.4. Факторы, влияющие на баланс и дисбаланс микробиоты
2.4.1. Диета и образ жизни. Кишечно-мозговая ось
2.4.2. Антибиотикотерапия
2.4.3. Эпигенетическое взаимодействие с микробиотой. Эндокринные разрушители
2.4.4. Пробиотики, пребиотики, симбиотики. Концепции и общие положения
2.4.5. Фекальная трансплантация, последние достижения
Модуль 3. Микробиота и иммунная система
3.1. Физиология иммунной системы
3.1.1. Составляющие иммунной системы
3.1.1.1. Лимфоидная ткань
3.1.1.2. Иммунные клетки
3.1.1.3. Химические системы
3.1.2. Органы, задействованные в иммунитете
3.1.2.1. Первичные органы
3.1.2.2. Вторичные органы
3.1.3. Врожденный, неспецифический или естественный иммунитет
3.1.4. Приобретенный, адаптивный или специфический иммунитет
3.2. Питание и образ жизни
3.3. Функциональные продукты питания (пробиотики и пребиотики), нутрицевтики и иммунная система
3.3.1. Пробиотики, пребиотики и симбиотики
3.3.2. Нутрицевтики и функциональные продукты питания
3.4. Двунаправленная связь между микробиотой и нейроиммуноэндокринной системой
3.5. Микробиота, иммунитет и расстройства нервной системы
3.6. Ось микробиота-кишечник-мозг
3.7. Текущие направления исследований
Воспользуйтесь возможностью узнать о последних достижениях в этой области и применить их в своей повседневной практике"
Курс профессиональной подготовки в области микробиоты кожи
TECH Технологический университет представляет Курс профессиональной подготовки по микробиоте кожи - новой и увлекательной области в сфере питания и ухода за кожей. Узнайте, как баланс микроорганизмов в нашей коже играет фундаментальную роль в здоровье и благополучии. Наши онлайн-занятия предлагают вам удобство и гибкость, позволяя учиться из любого места и в любое время. Воспользуйтесь преимуществами виртуального образования и получите доступ к специализированному, передовому содержанию по микробиоте кожи под руководством экспертов в этой области. Благодаря нашим онлайн-занятиям вы сможете организовать свой учебный график в соответствии с вашими потребностями и поддерживать баланс между личной и профессиональной жизнью. Программа Курса профессиональной подготовки даст вам знания, необходимые для понимания взаимодействия между микроорганизмами и кожей, а также факторов, которые могут повлиять на баланс микробиоты кожи. Вы узнаете о последних исследованиях и достижениях в этой области, а также о том, как применять эти знания для поддержания здоровья и сияния кожи.
Специализируйтесь в области микробиоты кожи
Микробиота кожи играет важнейшую роль в защите нашего кожного барьера и предотвращении инфекций и заболеваний. Благодаря этой программе вы окажетесь на переднем крае диетологии и ухода за кожей, приобретя навыки консультирования своих клиентов или пациентов о том, как поддерживать сбалансированную микробиоту и способствовать здоровью кожи. В TECH Технологическом университете работает команда лекторов-экспертов по микробиоте кожи, которые проведут вас по программе и ответят на ваши вопросы и запросы. Кроме того, у вас будет доступ к высококачественным ресурсам и учебным материалам, которые помогут вам углубить понимание ключевых концепций и применить их в реальных жизненных ситуациях. Не упустите возможность стать эталоном в области изучения микробиоты кожи. Присоединяйтесь к TECH Технологическому университету.







